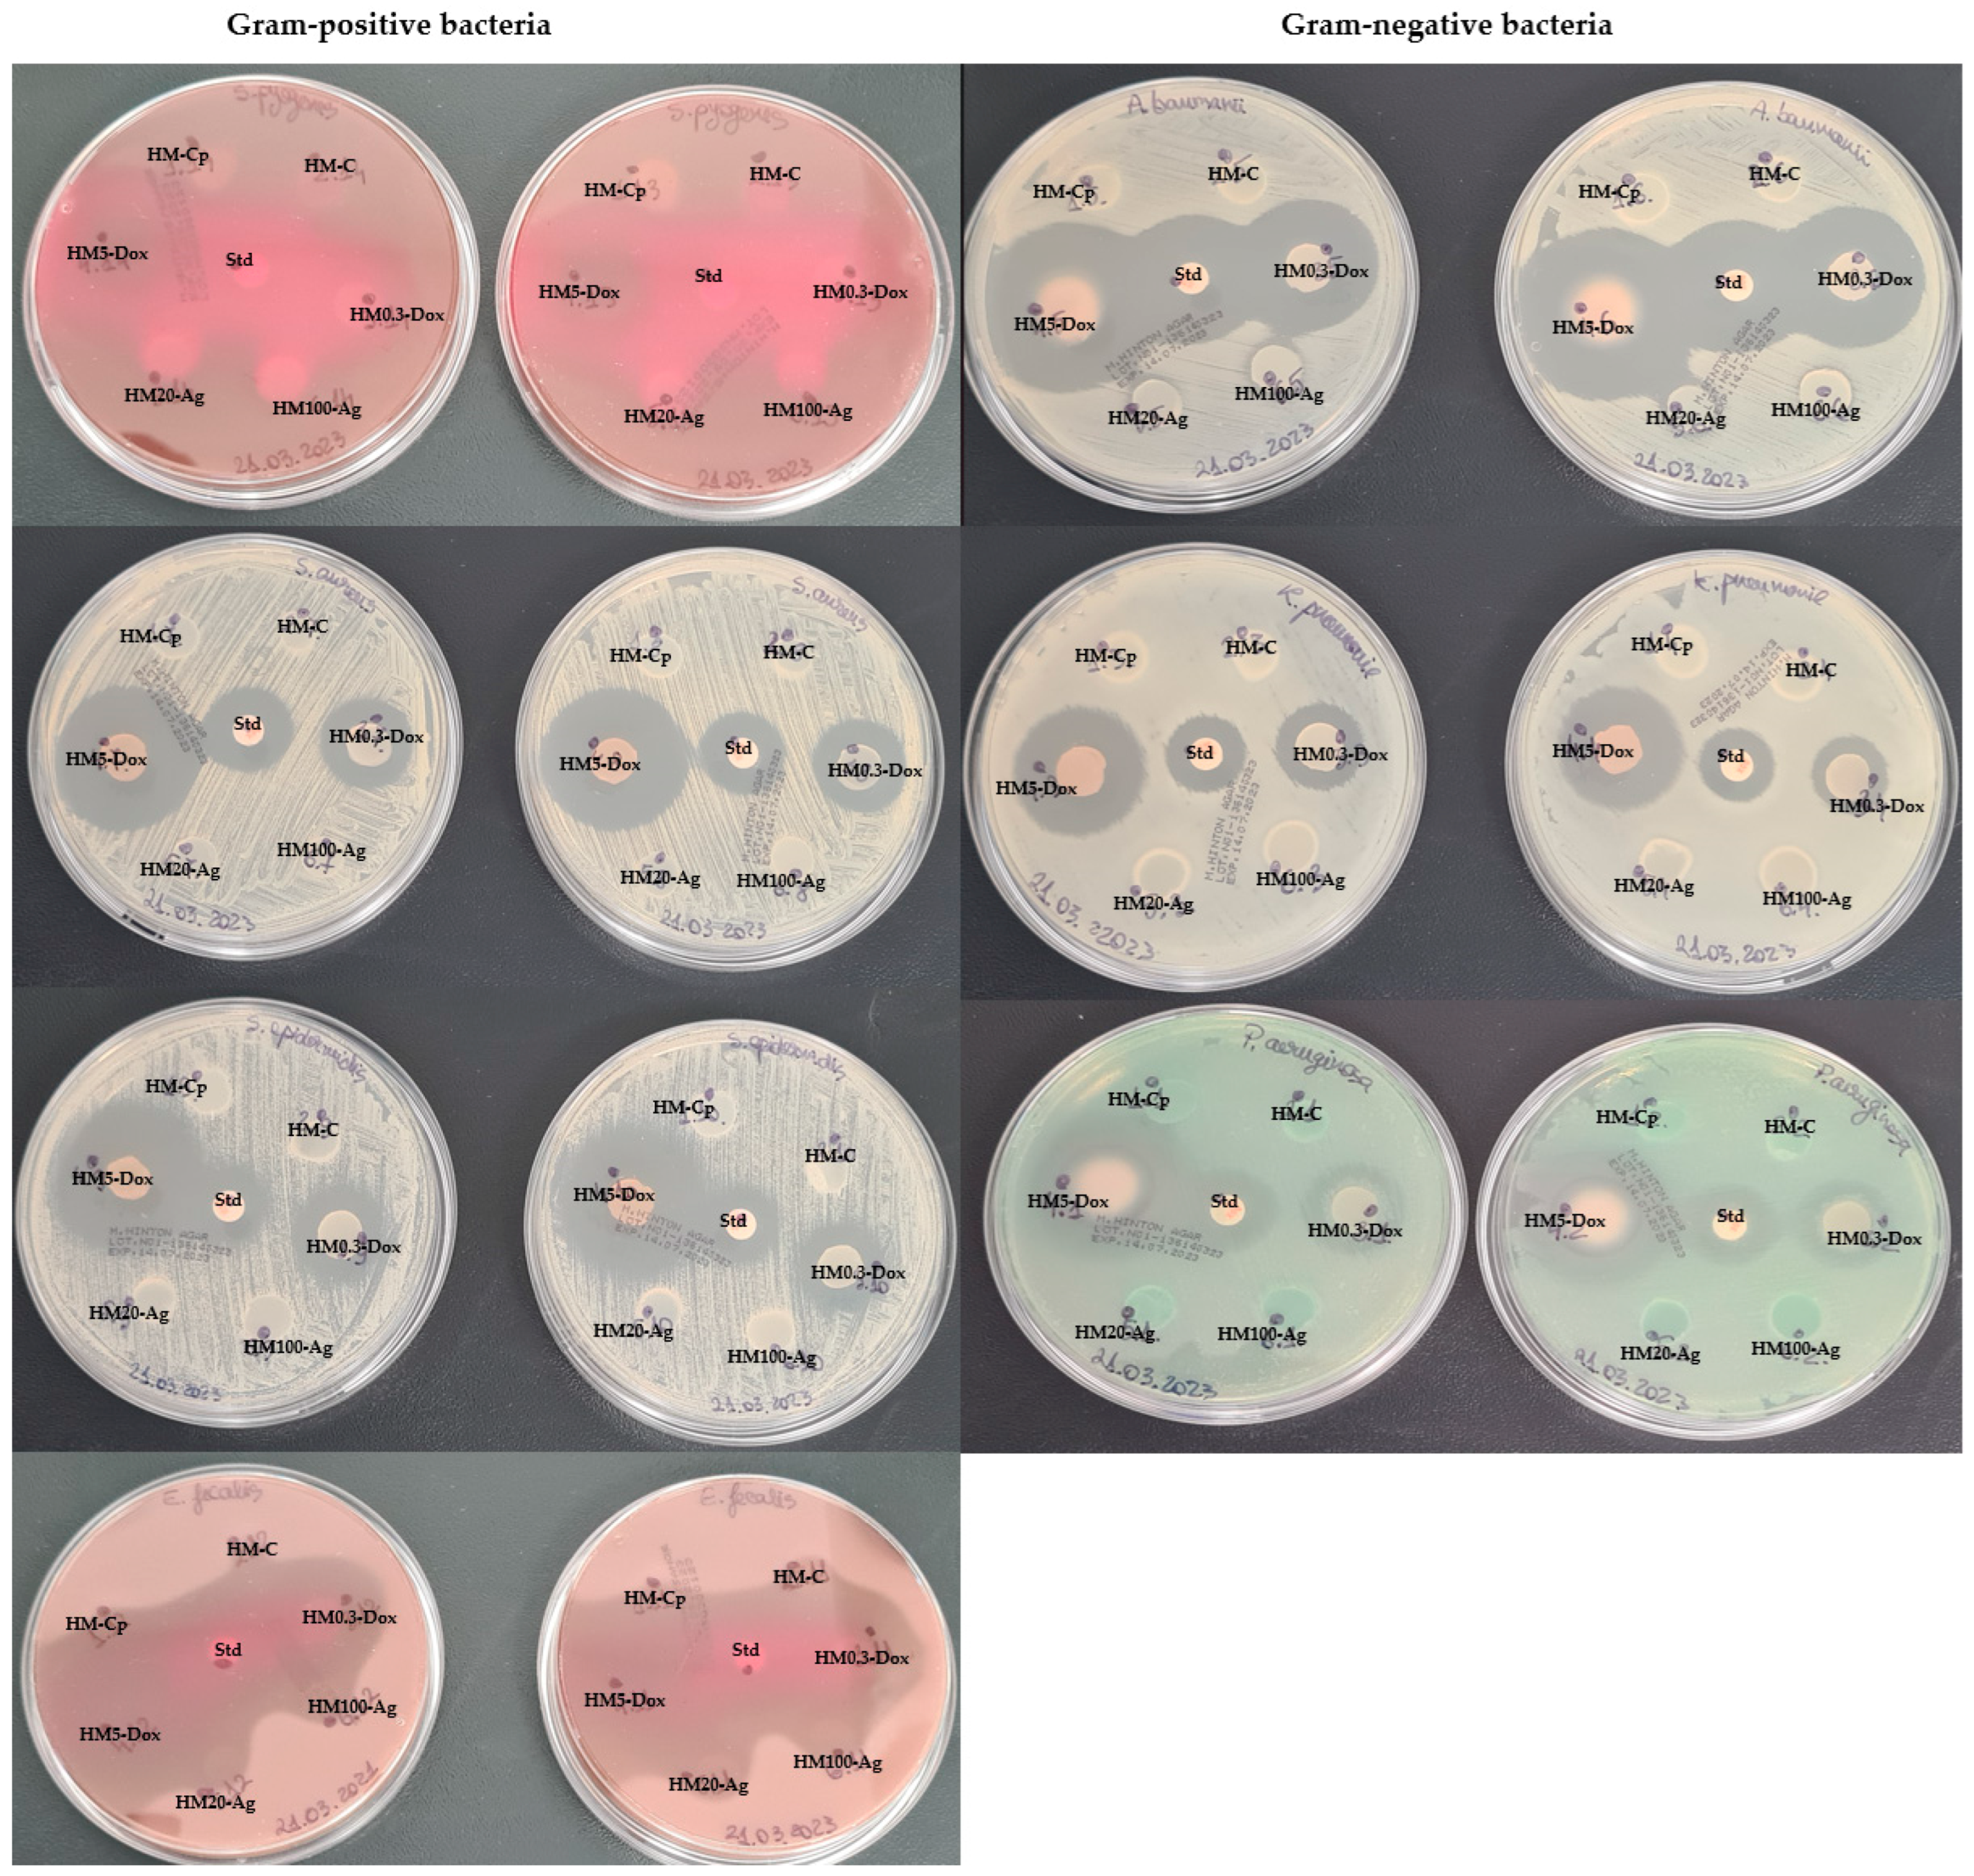

Formulation and Comprehensive Evaluation of Biohybrid Hydrogel Membranes Containing Doxycycline or Silver Nanoparticles
Abstract
:1. Introduction
2. Materials and Methods
2.1. Chemicals and Reagents
2.2. Bacterial Strains and Culture Media
2.3. Equipment
2.4. Biohybrid Hydrogel Membrane Production
2.5. Macroscopic Evaluation and pH
2.6. Swelling Index
2.7. Water Vapor Uptake
2.8. Gel Fraction
2.9. Degradation Study
2.10. Dynamic Rheology Measurements
2.11. Antioxidant Activity
2.12. Inhibition of Protein Denaturation
2.13. Doxycycline Release Study
2.13.1. Cumulative Doxycycline Release
2.13.2. Release Kinetic Study
- Zero-order modelwhere Ct represents the drug amount dissolved at time t; C0 is the initial drug amount, and K0 is the zero-order release constant in concentration/time units. To analyze release kinetics, data from in vitro drug release studies were graphed as cumulative released drug amount against time [69].Ct = C0 + K0t,
- First order modellnCt = lnC0 − K1t,
- Higuchi modelQ = Kt0.5
- Korsmeyer–Peppas modelCt/C∞ = K × tn
2.14. Antibacterial Activity
2.15. Biocompatibility Study
2.15.1. Protein Adsorption
2.15.2. Cell Culture and Scratch-Wound Assay
2.15.3. Cell Proliferation Assay
2.16. Surface Morphology
2.17. Statistical Analysis
3. Results and Discussion
3.1. Production of Biohybrid Hydrogel Membranes
3.2. Macroscopic Evaluation and pH
3.3. Swelling Index
3.4. Water Vapor Uptake
3.5. Gel Fraction
3.6. Degradation Study
3.7. Oscillatory Rheology—Frequency Sweep Tests
3.8. Antioxidant Activity
3.9. Anti-Inflammatory Activity
3.10. Doxycycline Release Study
3.10.1. Cumulative Doxycycline Release
3.10.2. Release Kinetic Study
3.11. Antimicrobial Analysis
3.12. Biocompatibility Study
3.12.1. Protein Adsorption
3.12.2. Cell Proliferation Assay
3.12.3. Cell Migration Assay
3.13. Surface Morphology Analysis
4. Conclusions
Author Contributions
Funding
Institutional Review Board Statement
Informed Consent Statement
Data Availability Statement
Acknowledgments
Conflicts of Interest
Appendix A
| Susceptible | Intermediate | Resistant | |
|---|---|---|---|
| Streptococcus spp. | ≥23 | 19–22 | ≤18 |
| Staphylococcus spp. | ≥16 | 13–15 | ≤12 |
| Enterococcus spp. | ≥16 | 13–15 | ≤12 |
| Acinetobacter spp. | ≥13 | 10–12 | ≤9 |
| Enterobacterales | ≥14 | 11–13 | ≤10 |

References
- Tottoli, E.M.; Dorati, R.; Genta, I.; Chiesa, E.; Pisani, S.; Conti, B. Skin Wound Healing Process and New Emerging Technologies for Skin Wound Care and Regeneration. Pharmaceutics 2020, 12, 735. [Google Scholar] [CrossRef] [PubMed]
- Rezvani Ghomi, E.; Niazi, M.; Ramakrishna, S. The Evolution of Wound Dressings: From Traditional to Smart Dressings. Polym. Adv. Technol. 2023, 34, 520–530. [Google Scholar] [CrossRef]
- Hydrogel Market Trends, Analysis. Forecast Report, 2032. Available online: https://www.gminsights.com/industry-analysis/hydrogel-market (accessed on 14 September 2023).
- Hydrogel Market—Size, Report & Overview. Available online: https://www.mordorintelligence.com/industry-reports/hydrogel-market (accessed on 14 September 2023).
- Augustine, R.; Hasan, A.; Dalvi, Y.B.; Rehman, S.R.U.; Varghese, R.; Unni, R.N.; Yalcin, H.C.; Alfkey, R.; Thomas, S.; Al Moustafa, A.-E. Growth Factor Loaded in Situ Photocrosslinkable Poly(3-Hydroxybutyrate-Co-3-Hydroxyvalerate)/Gelatin Methacryloyl Hybrid Patch for Diabetic Wound Healing. Mater. Sci. Eng. C 2021, 118, 111519. [Google Scholar] [CrossRef]
- Rezaei, N.; Hamidabadi, H.G.; Khosravimelal, S.; Zahiri, M.; Ahovan, Z.A.; Bojnordi, M.N.; Eftekhari, B.S.; Hashemi, A.; Ganji, F.; Darabi, S.; et al. Antimicrobial Peptides-Loaded Smart Chitosan Hydrogel: Release Behavior and Antibacterial Potential against Antibiotic Resistant Clinical Isolates. Int. J. Biol. Macromol. 2020, 164, 855–862. [Google Scholar] [CrossRef]
- Hu, Y.; Yu, B.; Jia, Y.; Lei, M.; Li, Z.; Liu, H.; Huang, H.; Xu, F.; Li, J.; Wei, Z. Hyaluronate- and Gelatin-Based Hydrogels Encapsulating Doxycycline as a Wound Dressing for Burn Injury Therapy. Acta Biomater. 2023, 164, 151–158. [Google Scholar] [CrossRef]
- Morgado, P.I.; Miguel, S.P.; Correia, I.J.; Aguiar-Ricardo, A. Ibuprofen Loaded PVA/Chitosan Membranes: A Highly Efficient Strategy towards an Improved Skin Wound Healing. Carbohydr. Polym. 2017, 159, 136–145. [Google Scholar] [CrossRef] [PubMed]
- Gavan, A.; Colobatiu, L.; Hanganu, D.; Bogdan, C.; Olah, N.K.; Achim, M.; Mirel, S. Development and Evaluation of Hydrogel Wound Dressings Loaded with Herbal Extracts. Processes 2022, 10, 242. [Google Scholar] [CrossRef]
- Meamar, R.; Ghasemi-Mobarakeh, L.; Norouzi, M.-R.; Siavash, M.; Hamblin, M.R.; Fesharaki, M. Improved Wound Healing of Diabetic Foot Ulcers Using Human Placenta-Derived Mesenchymal Stem Cells in Gelatin Electrospun Nanofibrous Scaffolds plus a Platelet-Rich Plasma Gel: A Randomized Clinical Trial. Int. Immunopharmacol. 2021, 101, 108282. [Google Scholar] [CrossRef]
- Mousavi, S.; Khoshfetrat, A.B.; Khatami, N.; Ahmadian, M.; Rahbarghazi, R. Comparative Study of Collagen and Gelatin in Chitosan-Based Hydrogels for Effective Wound Dressing: Physical Properties and Fibroblastic Cell Behavior. Biochem. Biophys. Res. Commun. 2019, 518, 625–631. [Google Scholar] [CrossRef] [PubMed]
- Patel, R.S.; Parmar, M. Doxycycline Hyclate. In StatPearls; StatPearls Publishing: St. Petersburg, FL, USA, 2023. [Google Scholar]
- Sapadin, A.N.; Fleischmajer, R. Tetracyclines: Nonantibiotic Properties and Their Clinical Implications. J. Am. Acad. Dermatol. 2006, 54, 258–265. [Google Scholar] [CrossRef] [PubMed]
- Golub, L.M.; Lee, H.M.; Ryan, M.E.; Giannobile, W.V.; Payne, J.; Sorsa, T. Tetracyclines Inhibit Connective Tissue Breakdown by Multiple Non-Antimicrobial Mechanisms. Adv. Dent. Res. 1998, 12, 12–26. [Google Scholar] [CrossRef] [PubMed]
- Anumolu, S.S.; Menjoge, A.R.; Deshmukh, M.; Gerecke, D.; Stein, S.; Laskin, J.; Sinko, P.J. Doxycycline Hydrogels with Reversible Disulfide Crosslinks for Dermal Wound Healing of Mustard Injuries. Biomaterials 2011, 32, 1204–1217. [Google Scholar] [CrossRef]
- Weinberg, J.M. The Anti-Inflammatory Effects of Tetracyclines. Cutis 2005, 75, 6–11. [Google Scholar] [PubMed]
- Bikowski, J.B. Subantimicrobial Dose Doxycycline for Acne and Rosacea. Skinmed Dermatol. Clin. 2003, 2, 234–245. [Google Scholar] [CrossRef]
- Anti-Inflammatory Effects of Tetracyclines—Schaller—2017—Journal of the European Academy of Dermatology and Venereology—Wiley Online Library. Available online: https://onlinelibrary.wiley.com/doi/full/10.1111/jdv.14641 (accessed on 28 August 2023).
- Stechmiller, J.; Cowan, L.; Schultz, G. The Role of Doxycycline as a Matrix Metalloproteinase Inhibitor for the Treatment of Chronic Wounds. Biol. Res. Nurs. 2010, 11, 336–344. [Google Scholar] [CrossRef] [PubMed]
- Mendes, C.; Thirupathi, A.; Corrêa, M.E.A.B.; Gu, Y.; Silveira, P.C.L. The Use of Metallic Nanoparticles in Wound Healing: New Perspectives. Int. J. Mol. Sci. 2022, 23, 15376. [Google Scholar] [CrossRef] [PubMed]
- Nam, G.; Rangasamy, S.; Purushothaman, B.; Song, J.M. The Application of Bactericidal Silver Nanoparticles in Wound Treatment. Nanomater. Nanotechnol. 2015, 5, 23. [Google Scholar] [CrossRef]
- Yin, I.X.; Zhang, J.; Zhao, I.S.; Mei, M.L.; Li, Q.; Chu, C.H. The Antibacterial Mechanism of Silver Nanoparticles and Its Application in Dentistry. Int. J. Nanomed. 2020, 15, 2555–2562. [Google Scholar] [CrossRef]
- Lin, J.; Miao, L.; Zhong, G.; Lin, C.-H.; Dargazangy, R.; Alexander-Katz, A. Understanding the Synergistic Effect of Physicochemical Properties of Nanoparticles and Their Cellular Entry Pathways. Commun. Biol. 2020, 3, 1–10. [Google Scholar] [CrossRef]
- Pal, S.; Tak, Y.K.; Song, J.M. Does the Antibacterial Activity of Silver Nanoparticles Depend on the Shape of the Nanoparticle? A Study of the Gram-Negative Bacterium Escherichia Coli. Appl. Environ. Microbiol. 2007, 73, 1712–1720. [Google Scholar] [CrossRef]
- Carlson, C.; Hussain, S.M.; Schrand, A.M.; Braydich-Stolle, L.K.; Hess, K.L.; Jones, R.L.; Schlager, J.J. Unique Cellular Interaction of Silver Nanoparticles: Size-Dependent Generation of Reactive Oxygen Species. J. Phys. Chem. B 2008, 112, 13608–13619. [Google Scholar] [CrossRef] [PubMed]
- Kim, T.-H.; Kim, M.; Park, H.S.; Shin, U.; Gong, M.-S.; Kim, H.-W. Size-Dependent Cellular Toxicity of Silver Nanoparticles. J. Biomed. Mater. Res. Part. A 2012, 100, 1033–1043. [Google Scholar] [CrossRef] [PubMed]
- Agnihotri, S.; Mukherji, S.; Mukherji, S. Size-Controlled Silver Nanoparticles Synthesized over the Range 5–100 Nm Using the Same Protocol and Their Antibacterial Efficacy. RSC Adv. 2014, 4, 3974–3983. [Google Scholar] [CrossRef]
- Ambrožová, N.; Zálešák, B.; Ulrichová, J.; Čížková, K.; Galandáková, A. Low Concentrations of Silver Nanoparticles Have a Beneficial Effect on Wound Healing in Vitro. J. Nanopart Res. 2017, 19, 108. [Google Scholar] [CrossRef]
- Antifungal, Antiviral, and Antibacterial Activities of Silver Nanoparticles Synthesized Using Fungi: A Review. Lett. Appl. NanoBioSci. 2020, 9, 1307–1312. [CrossRef]
- Shang, L.; Nienhaus, K.; Nienhaus, G.U. Engineered Nanoparticles Interacting with Cells: Size Matters. J. Nanobiotechnol. 2014, 12, 5. [Google Scholar] [CrossRef] [PubMed]
- Wu, M.; Guo, H.; Liu, L.; Liu, Y.; Xie, L. Size-Dependent Cellular Uptake and Localization Profiles of Silver Nanoparticles. Int. J. Nanomed. 2019, 14, 4247–4259. [Google Scholar] [CrossRef] [PubMed]
- Zhao, J.; Stenzel, M.H. Entry of Nanoparticles into Cells: The Importance of Nanoparticle Properties. Polym. Chem. 2018, 9, 259–272. [Google Scholar] [CrossRef]
- Beer, C.; Foldbjerg, R.; Hayashi, Y.; Sutherland, D.S.; Autrup, H. Toxicity of Silver Nanoparticles—Nanoparticle or Silver Ion? Toxicol. Lett. 2012, 208, 286–292. [Google Scholar] [CrossRef]
- Kobos, L.; Alqahtani, S.; Xia, L.; Coltellino, V.; Kishman, R.; McIlrath, D.; Perez-Torres, C.; Shannahan, J. Comparison of Silver Nanoparticle-Induced Inflammatory Responses Between Healthy and Metabolic Syndrome Mouse Models. J. Toxicol. Environ. Health A 2020, 83, 249–268. [Google Scholar] [CrossRef]
- Lankveld, D.P.K.; Oomen, A.G.; Krystek, P.; Neigh, A.; Troost—De Jong, A.; Noorlander, C.W.; Van Eijkeren, J.C.H.; Geertsma, R.E.; De Jong, W.H. The Kinetics of the Tissue Distribution of Silver Nanoparticles of Different Sizes. Biomaterials 2010, 31, 8350–8361. [Google Scholar] [CrossRef]
- Noga, M.; Milan, J.; Frydrych, A.; Jurowski, K. Toxicological Aspects, Safety Assessment, and Green Toxicology of Silver Nanoparticles (AgNPs)—Critical Review: State of the Art. Int. J. Mol. Sci. 2023, 24, 5133. [Google Scholar] [CrossRef] [PubMed]
- Olugbodi, J.O.; Lawal, B.; Bako, G.; Onikanni, A.S.; Abolenin, S.M.; Mohammud, S.S.; Ataya, F.S.; Batiha, G.E.-S. Effect of Sub-Dermal Exposure of Silver Nanoparticles on Hepatic, Renal and Cardiac Functions Accompanying Oxidative Damage in Male Wistar Rats. Sci. Rep. 2023, 13, 10539. [Google Scholar] [CrossRef] [PubMed]
- Bastos, V.; Ferreira de Oliveira, J.M.P.; Brown, D.; Jonhston, H.; Malheiro, E.; Daniel-da-Silva, A.L.; Duarte, I.F.; Santos, C.; Oliveira, H. The Influence of Citrate or PEG Coating on Silver Nanoparticle Toxicity to a Human Keratinocyte Cell Line. Toxicol. Lett. 2016, 249, 29–41. [Google Scholar] [CrossRef] [PubMed]
- Das, B.; Tripathy, S.; Adhikary, J.; Chattopadhyay, S.; Mandal, D.; Dash, S.K.; Das, S.; Dey, A.; Dey, S.K.; Das, D.; et al. Surface Modification Minimizes the Toxicity of Silver Nanoparticles: An in Vitro and in Vivo Study. J. Biol. Inorg. Chem. 2017, 22, 893–918. [Google Scholar] [CrossRef]
- Vega-Chacón, J.; Arbeláez, M.I.A.; Jorge, J.H.; Marques, R.F.C.; Jafelicci, M. pH-Responsive Poly(Aspartic Acid) Hydrogel-Coated Magnetite Nanoparticles for Biomedical Applications. Mater. Sci. Eng. C 2017, 77, 366–373. [Google Scholar] [CrossRef]
- Helmlinger, J.; Sengstock, C.; Groß-Heitfeld, C.; Mayer, C.; Schildhauer, A.T.; Köller, M.; Epple, M. Silver Nanoparticles with Different Size and Shape: Equal Cytotoxicity, but Different Antibacterial Effects. RSC Adv. 2016, 6, 18490–18501. [Google Scholar] [CrossRef]
- Menichetti, A.; Mavridi-Printezi, A.; Mordini, D.; Montalti, M. Effect of Size, Shape and Surface Functionalization on the Antibacterial Activity of Silver Nanoparticles. J. Funct. Biomater. 2023, 14, 244. [Google Scholar] [CrossRef]
- Agnihotri, S.; Mukherji, S.; Mukherji, S. Antimicrobial Chitosan–PVA Hydrogel as a Nanoreactor and Immobilizing Matrix for Silver Nanoparticles. Appl. Nanosci. 2012, 2, 179–188. [Google Scholar] [CrossRef]
- Bhowmick, S.; Koul, V. Assessment of PVA/Silver Nanocomposite Hydrogel Patch as Antimicrobial Dressing Scaffold: Synthesis, Characterization and Biological Evaluation. Mater. Sci. Eng. C 2016, 59, 109–119. [Google Scholar] [CrossRef]
- King, T.; Osmond-McLeod, M.J.; Duffy, L.L. Nanotechnology in the Food Sector and Potential Applications for the Poultry Industry. Trends Food Sci. Technol. 2018, 72, 62–73. [Google Scholar] [CrossRef]
- ISO/TS 13830:2013; 14:00–17:00. ISO: Geneva, Switzerland. Available online: https://www.iso.org/standard/54315.html (accessed on 12 October 2023).
- International Life Sciences Institute. Available online: https://ilsi.org/ (accessed on 12 October 2023).
- Nanosciences and Nanotechnologies: An Action Plan for Europe 2005–2009. Second Implementation Report 2007–2009.
- The Potential Risks Arising from Nanoscience and Nanotechnologies on Food and Feed Safety. EFSA. Available online: https://www.efsa.europa.eu/en/efsajournal/pub/958 (accessed on 12 October 2023).
- Zielińska, A.; Karczewski, J.; Eder, P.; Kolanowski, T.; Szalata, M.; Wielgus, K.; Szalata, M.; Kim, D.; Shin, S.R.; Słomski, R.; et al. Scaffolds for Drug Delivery and Tissue Engineering: The Role of Genetics. J. Control. Release 2023, 359, 207–223. [Google Scholar] [CrossRef] [PubMed]
- Coelho, J.F.; Ferreira, P.C.; Alves, P.; Cordeiro, R.; Fonseca, A.C.; Góis, J.R.; Gil, M.H. Drug Delivery Systems: Advanced Technologies Potentially Applicable in Personalized Treatments. EPMA J. 2010, 1, 164–209. [Google Scholar] [CrossRef] [PubMed]
- Erring, M.; Gaba, S.; Mohsina, S.; Tripathy, S.; Sharma, R.K. Comparison of Efficacy of Silver-Nanoparticle Gel, Nano-Silver-Foam and Collagen Dressings in Treatment of Partial Thickness Burn Wounds. Burns 2019, 45, 1888–1894. [Google Scholar] [CrossRef] [PubMed]
- Eskitoros-Togay, Ş.M.; Bulbul, Y.E.; Dilsiz, N. Controlled Release of Doxycycline within Core/Shell Poly(ε-Caprolactone)/Poly(Ethylene Oxide) Fibers via Coaxial Electrospinning. J. Appl. Polym. Sci. 2020, 137, 49273. [Google Scholar] [CrossRef]
- Abdallah, O.; Jalali, F.; Zamani, S.; Isamil, H.M.; Ma, S.; Nasrallah, G.K.; Younes, H.M. Fabrication & Characterization of 3D Electrospun Biodegradable Nanofibers for Wound Dressing, Drug Delivery and Other Tissue Engineering Applications. Pharm. Nanotechnol. 2016, 4, 191–201. [Google Scholar] [PubMed]
- Lu, H.-T.; Sheu, M.-T.; Lin, Y.-F.; Lan, J.; Chin, Y.-P.; Hsieh, M.-S.; Cheng, C.-W.; Chen, C.-H. Injectable Hyaluronic-Acid-Doxycycline Hydrogel Therapy in Experimental Rabbit Osteoarthritis. BMC Vet. Res. 2013, 9, 68. [Google Scholar] [CrossRef]
- Zhao, X.; Yang, Y.; Yu, J.; Ding, R.; Pei, D.; Zhang, Y.; He, G.; Cheng, Y.; Li, A. Injectable Hydrogels with High Drug Loading through B-N Coordination and ROS-Triggered Drug Release for Efficient Treatment of Chronic Periodontitis in Diabetic Rats. Biomaterials 2022, 282, 121387. [Google Scholar] [CrossRef]
- Liang, Y.; Zhao, X.; Hu, T.; Han, Y.; Guo, B. Mussel-Inspired, Antibacterial, Conductive, Antioxidant, Injectable Composite Hydrogel Wound Dressing to Promote the Regeneration of Infected Skin. J. Colloid. Interface Sci. 2019, 556, 514–528. [Google Scholar] [CrossRef]
- Dong, M.; Mao, Y.; Zhao, Z.; Zhang, J.; Zhu, L.; Chen, L.; Cao, L. Novel Fabrication of Antibiotic Containing Multifunctional Silk Fibroin Injectable Hydrogel Dressing to Enhance Bactericidal Action and Wound Healing Efficiency on Burn Wound: In Vitro and in Vivo Evaluations. Int. Wound J. 2022, 19, 679–691. [Google Scholar] [CrossRef]
- Ndlovu, S.P.; Fonkui, T.Y.; Ndinteh, D.T.; Aderibigbe, B.A. Dissolvable Wound Dressing Loaded with Silver Nanoparticles Together with Ampicillin and Ciprofloxacin. Ther. Deliv. 2022, 13, 295–311. [Google Scholar] [CrossRef] [PubMed]
- Stan, D.; Codrici, E.; Enciu, A.-M.; Olewnik-Kruszkowska, E.; Gavril, G.; Ruta, L.L.; Moldovan, C.; Brincoveanu, O.; Bocancia-Mateescu, L.-A.; Mirica, A.-C.; et al. Exploring the Impact of Alginate—PVA Ratio and the Addition of Bioactive Substances on the Performance of Hybrid Hydrogel Membranes as Potential Wound Dressings. Gels 2023, 9, 476. [Google Scholar] [CrossRef] [PubMed]
- Ritger, P.L.; Peppas, N.A. A Simple Equation for Description of Solute Release I. Fickian and Non-Fickian Release from Non-Swellable Devices in the Form of Slabs, Spheres, Cylinders or Discs. J. Control. Release 1987, 5, 23–36. [Google Scholar] [CrossRef]
- Arafa, A.A.; Nada, A.A.; Ibrahim, A.Y.; Zahran, M.K.; Hakeim, O.A. Greener Therapeutic pH-Sensing Wound Dressing Based on Curcuma Longa and Cellulose Hydrogel. Eur. Polym. J. 2021, 159, 110744. [Google Scholar] [CrossRef]
- Barleany, D.R.; Ananta, C.; Maulina, F.; Rochmat, A.; Alwan, H.; Erizal, E. Controlled Release of Metformin Hydrogen Chloride from Stimuli-Responsive Hydrogel Based on Poly(N-Isopropylacrylamide)/Chitosan/Polyvinyl Alcohol Composite. Int. J. Technol. 2020, 11, 511. [Google Scholar] [CrossRef]
- Chopra, H.; Bibi, S.; Kumar, S.; Khan, M.S.; Kumar, P.; Singh, I. Preparation and Evaluation of Chitosan/PVA Based Hydrogel Films Loaded with Honey for Wound Healing Application. Gels 2022, 8, 111. [Google Scholar] [CrossRef] [PubMed]
- Wu, N.; Yu, H.; Sun, M.; Li, Z.; Zhao, F.; Ao, Y.; Chen, H. Investigation on the Structure and Mechanical Properties of Highly Tunable Elastomeric Silk Fibroin Hydrogels Cross-Linked by Gamma-Ray Radiation. ACS Appl. Bio Mater. 2019, 3, 721–734. [Google Scholar] [CrossRef]
- Sasikala, L.; Durai, B.; Rathinamoorthy, R.; Author, C. Manuka Honey Loaded Chitosan Hydrogel Films for Wound Dressing Applications. Int. J. PharmTech Res. 2013, 5, 1774–1785. [Google Scholar]
- Kang, B.; Vales, T.P.; Cho, B.-K.; Kim, J.-K.; Kim, H.-J. Development of Gallic Acid-Modified Hydrogels Using Interpenetrating Chitosan Network and Evaluation of Their Antioxidant Activity. Molecules 2017, 22, 1976. [Google Scholar] [CrossRef]
- Nowak, A.; Zagórska-Dziok, M.; Perużyńska, M.; Cybulska, K.; Kucharska, E.; Ossowicz-Rupniewska, P.; Piotrowska, K.; Duchnik, W.; Kucharski, Ł.; Sulikowski, T.; et al. Assessment of the Anti-Inflammatory, Antibacterial and Anti-Aging Properties and Possible Use on the Skin of Hydrogels Containing Epilobium angustifolium L. Extracts. Front. Pharmacol. 2022, 13, 896706. [Google Scholar] [CrossRef]
- Dash, S.; Murthy, P.N.; Nath, L.; Chowdhury, P. Kinetic Modeling on Drug Release from Controlled Drug Delivery Systems. Acta Pol. Pharm. 2010, 67, 217–223. [Google Scholar]
- Delavari, M.M.; Stiharu, I. Preparation and Characterization of Eco-Friendly Transparent Antibacterial Starch/Polyvinyl Alcohol Materials for Use as Wound-Dressing. Micromachines 2022, 13, 960. [Google Scholar] [CrossRef]
- Gago, D.; Corvo, M.C.; Chagas, R.; Ferreira, L.M.; Coelhoso, I. Protein Adsorption Performance of a Novel Functionalized Cellulose-Based Polymer. Polymers 2022, 14, 5122. [Google Scholar] [CrossRef] [PubMed]
- Augustine, R.; Dan, P.; Schlachet, I.; Rouxel, D.; Menu, P.; Sosnik, A. Chitosan Ascorbate Hydrogel Improves Water Uptake Capacity and Cell Adhesion of Electrospun Poly(Epsilon-Caprolactone) Membranes. Int. J. Pharm. 2019, 559, 420–426. [Google Scholar] [CrossRef] [PubMed]
- Saif, A.B.; Jabbar, S.; Akhtar, M.S.; Mushtaq, A.; Tariq, M. Effects of Topical Vancomycin Dressing on Methicillin-Resistant Staphylococcus Aureus (MRSA) Positive Diabetic Foot Ulcers. Pak. J. Med. Sci. 2019, 35, 1099–1103. [Google Scholar] [CrossRef]
- Chen, H.; Li, B.; Feng, B.; Wang, H.; Yuan, H.; Xu, Z. Tetracycline Hydrochloride Loaded Citric Acid Functionalized Chitosan Hydrogel for Wound Healing. RSC Adv. 2019, 9, 19523–19530. [Google Scholar] [CrossRef] [PubMed]
- Movassaghi, S.; Nadia Sharifi, Z.; Koosha, M.; Abdollahifar, M.A.; Fathollahipour, S.; Tavakoli, J.; Abdi, S. Effect of Honey/PVA Hydrogel Loaded by Erythromycin on Full-Thickness Skin Wound Healing in Rats; Stereological Study. Galen. Med. J. 2019, 8, e1362. [Google Scholar] [CrossRef]
- Kowalczuk, D.; Miazga-Karska, M.; Gładysz, A.; Warda, P.; Barańska, A.; Drop, B. Characterization of Ciprofloxacin-Bismuth-Loaded Antibacterial Wound Dressing. Molecules 2020, 25, 5096. [Google Scholar] [CrossRef]
- Heydari, P.; Zargar Kharazi, A.; Asgary, S.; Parham, S. Comparing the Wound Healing Effect of a Controlled Release Wound Dressing Containing Curcumin/Ciprofloxacin and Simvastatin/Ciprofloxacin in a Rat Model: A Preclinical Study. J. Biomed. Mater. Res. A 2022, 110, 341–352. [Google Scholar] [CrossRef] [PubMed]
- AlSalem, H.S.; Bukhari, A.A.H. Biodegradable Wound Dressing-Based Collagen/Hyaluronic Acid Loaded Antibacterial Agents for Wound Healing Application. Int. J. Biol. Macromol. 2023, 242, 124700. [Google Scholar] [CrossRef]
- Tort, S.; Acartürk, F.; Beşikci, A. Evaluation of Three-Layered Doxycycline-Collagen Loaded Nanofiber Wound Dressing. Int. J. Pharm. 2017, 529, 642–653. [Google Scholar] [CrossRef]
- Ardika, K.A.R.; Marzaman, A.N.F.; Kaharuddin, K.M.; Parenden, M.D.K.; Karimah, A.; Musfirah, C.A.; Pakki, E.; Permana, A.D. Development of Chitosan-Hyaluronic Acid Based Hydrogel for Local Delivery of Doxycycline Hyclate in an Ex Vivo Skin Infection Model. J. Biomater. Sci. Polym. Ed. 2023, 34, 2274–2290. [Google Scholar] [CrossRef] [PubMed]
- Hedayatyanfard, K.; Bagheri Khoulenjani, S.; Abdollahifar, M.A.; Amani, D.; Habibi, B.; Zare, F.; Asadirad, A.; Pouriran, R.; Ziai, S.A. Chitosan/PVA/Doxycycline Film and Nanofiber Accelerate Diabetic Wound Healing in a Rat Model. Iran. J. Pharm. Res. 2020, 19, 225–239. [Google Scholar] [CrossRef] [PubMed]
- Amante, C.; Esposito, T.; Del Gaudio, P.; Di Sarno, V.; Porta, A.; Tosco, A.; Russo, P.; Nicolais, L.; Aquino, R.P. A Novel Three-Polysaccharide Blend In Situ Gelling Powder for Wound Healing Applications. Pharmaceutics 2021, 13, 1680. [Google Scholar] [CrossRef] [PubMed]
- Adhirajan, N.; Shanmugasundaram, N.; Babu, M. Gelatin Microspheres Cross-Linked with EDC as a Drug Delivery System for Doxycyline: Development and Characterization. J. Microencapsul. 2007, 24, 647–659. [Google Scholar] [CrossRef] [PubMed]
- Patel, N.; Hatch, D.; Wells, C.M.; Ahn, D.; Harris, M.; Jennings, J.A.; Haggard, W.; Armstrong, D.G. Characteristics and Clinical Assessment of Antibiotic Delivery by Chitosan Sponge in the High-Risk Diabetic Foot: A Case Series. J. Wound Care 2017, 26, S32–S38. [Google Scholar] [CrossRef] [PubMed]
- Sulastri, E.; Lesmana, R.; Zubair, M.S.; Abdelwahab Mohammed, A.F.; Elamin, K.M.; Wathoni, N. Ulvan/Silver Nanoparticle Hydrogel Films for Burn Wound Dressing. Heliyon 2023, 9, e18044. [Google Scholar] [CrossRef] [PubMed]
- GhavamiNejad, A.; Rajan Unnithan, A.; Ramachandra Kurup Sasikala, A.; Samarikhalaj, M.; Thomas, R.G.; Jeong, Y.Y.; Nasseri, S.; Murugesan, P.; Wu, D.; Hee Park, C.; et al. Mussel-Inspired Electrospun Nanofibers Functionalized with Size-Controlled Silver Nanoparticles for Wound Dressing Application. ACS Appl. Mater. Interfaces 2015, 7, 12176–12183. [Google Scholar] [CrossRef] [PubMed]
- Narayanan, K.B.; Han, S.S. Dual-Crosslinked Poly(Vinyl Alcohol)/Sodium Alginate/Silver Nanocomposite Beads—A Promising Antimicrobial Material. Food Chem. 2017, 234, 103–110. [Google Scholar] [CrossRef]
- Pangli, H.; Vatanpour, S.; Hortamani, S.; Jalili, R.; Ghahary, A. Incorporation of Silver Nanoparticles in Hydrogel Matrices for Controlling Wound Infection. J. Burn. Care Res. 2020, 42, 785–793. [Google Scholar] [CrossRef]
- Azizi-Lalabadi, M.; Garavand, F.; Jafari, S.M. Incorporation of Silver Nanoparticles into Active Antimicrobial Nanocomposites: Release Behavior, Analyzing Techniques, Applications and Safety Issues. Adv. Colloid. Interface Sci. 2021, 293, 102440. [Google Scholar] [CrossRef] [PubMed]
- Sim, P.; Strudwick, X.L.; Song, Y.; Cowin, A.J.; Garg, S. Influence of Acidic pH on Wound Healing In Vivo: A Novel Perspective for Wound Treatment. Int. J. Mol. Sci. 2022, 23, 13655. [Google Scholar] [CrossRef]
- Samadi, A.; Azandeh, S.; Orazizadeh, M.; Bayati, V.; Rafienia, M.; Karami, M.A. Fabrication and Characterization of Glycerol/Chitosan/Polyvinyl Alcohol-Based Transparent Hydrogel Films Loaded with Silver Nanoparticles for Antibacterial Wound Dressing Applications. Adv. Biomed. Res. 2021, 10, 4. [Google Scholar] [CrossRef]
- Boonkaew, B.; Suwanpreuksa, P.; Cuttle, L.; Barber, P.M.; Supaphol, P. Hydrogels Containing Silver Nanoparticles for Burn Wounds Show Antimicrobial Activity without Cytotoxicity. J. Appl. Polym. Sci. 2014, 131. [Google Scholar] [CrossRef]
- Aldakheel, F.M.; Mohsen, D.; El Sayed, M.M.; Alawam, K.A.; Binshaya, A.S.; Alduraywish, S.A. Silver Nanoparticles Loaded on Chitosan-g-PVA Hydrogel for the Wound-Healing Applications. Molecules 2023, 28, 3241. [Google Scholar] [CrossRef] [PubMed]
- Song, S.; Liu, Z.; Abubaker, M.A.; Ding, L.; Zhang, J.; Yang, S.; Fan, Z. Antibacterial Polyvinyl Alcohol/Bacterial Cellulose/Nano-Silver Hydrogels That Effectively Promote Wound Healing. Mater. Sci. Eng. C 2021, 126, 112171. [Google Scholar] [CrossRef]
- Yang, J.; Chen, Y.; Zhao, L.; Feng, Z.; Peng, K.; Wei, A.; Wang, Y.; Tong, Z.; Cheng, B. Preparation of a Chitosan/Carboxymethyl Chitosan/AgNPs Polyelectrolyte Composite Physical Hydrogel with Self-Healing Ability, Antibacterial Properties, and Good Biosafety Simultaneously, and Its Application as a Wound Dressing. Compos. Part. B Eng. 2020, 197, 108139. [Google Scholar] [CrossRef]
- Solbu, A.A.; Caballero, D.; Damigos, S.; Kundu, S.C.; Reis, R.L.; Halaas, Ø.; Chahal, A.S.; Strand, B.L. Assessing Cell Migration in Hydrogels: An Overview of Relevant Materials and Methods. Mater. Today Bio 2023, 18, 100537. [Google Scholar] [CrossRef]
- Patlolla, V.G.R.; Popovic, N.; Peter Holbrook, W.; Kristmundsdottir, T.; Gizurarson, S. Effect of Doxycycline Microencapsulation on Buccal Films: Stability, Mucoadhesion and In Vitro Drug Release. Gels 2021, 7, 51. [Google Scholar] [CrossRef]
- Szałaj, U.; Świderska-Środa, A.; Chodara, A.; Gierlotka, S.; Łojkowski, W. Nanoparticle Size Effect on Water Vapour Adsorption by Hydroxyapatite. Nanomaterials 2019, 9, 1005. [Google Scholar] [CrossRef] [PubMed]
- Helmiyati; Novientri, G.; Abbas, G.H.; Budianto, E. Nanocomposite Hydrogel-Based Biopolymer Modified with Silver Nanoparticles as an Antibacterial Material for Wound Treatment. J. App. Pharm. Sci. 2019, 9, 001–009. [Google Scholar] [CrossRef]
- Rodríguez Nuñez, Y.A.; Castro, R.I.; Arenas, F.A.; López-Cabaña, Z.E.; Carreño, G.; Carrasco-Sánchez, V.; Marican, A.; Villaseñor, J.; Vargas, E.; Santos, L.S.; et al. Preparation of Hydrogel/Silver Nanohybrids Mediated by Tunable-Size Silver Nanoparticles for Potential Antibacterial Applications. Polymers 2019, 11, 716. [Google Scholar] [CrossRef] [PubMed]
- PubChem Doxycycline. Available online: https://pubchem.ncbi.nlm.nih.gov/compound/54671203 (accessed on 27 August 2023).
- Alcântara, M.T.S.; Lincopan, N.; Santos, P.M.; Ramirez, P.A.; Brant, A.J.C.; Riella, H.G.; Lugão, A.B. Simultaneous Hydrogel Crosslinking and Silver Nanoparticle Formation by Using Ionizing Radiation to Obtain Antimicrobial Hydrogels. Radiat. Phys. Chem. 2020, 169, 108777. [Google Scholar] [CrossRef]
- Popescu, I.; Constantin, M.; Pelin, I.M.; Suflet, D.M.; Ichim, D.L.; Daraba, O.M.; Fundueanu, G. Eco-Friendly Synthesized PVA/Chitosan/Oxalic Acid Nanocomposite Hydrogels Embedding Silver Nanoparticles as Antibacterial Materials. Gels 2022, 8, 268. [Google Scholar] [CrossRef]
- Mohamadinia, P. Preparation and Characterization of Sodium Alginate/Acrylic Acid Composite Hydrogels Conjugated to Silver Nanoparticles As An Antibiotic Delivery System. Green Process. Synth. 2021, 10, 860–873. [Google Scholar] [CrossRef]
- Qiu, Y.; Sun, X.; Lin, X.; Yi, W.; Jiang, J. An Injectable Metal Nanoparticle Containing Cellulose Derivative-based Hydrogels: Evaluation of Antibacterial and in Vitro-vivo Wound Healing Activity in Children with Burn Injuries. Int. Wound J. 2021, 19, 666–678. [Google Scholar] [CrossRef]
- Kamoun, E.A.; Kenawy, E.-R.S.; Tamer, T.M.; El-Meligy, M.A.; Mohy Eldin, M.S. Poly (Vinyl Alcohol)-Alginate Physically Crosslinked Hydrogel Membranes for Wound Dressing Applications: Characterization and Bio-Evaluation. Arab. J. Chem. 2015, 8, 38–47. [Google Scholar] [CrossRef]
- Wassenaar, J.W.; Braden, R.L.; Osborn, K.G.; Christman, K.L. Modulating in Vivo Degradation Rate of Injectable Extracellular Matrix Hydrogels. J. Mater. Chem. B 2016, 4, 2794–2802. [Google Scholar] [CrossRef]
- Coupland, J.N. An Introduction to the Physical Chemistry of Food; Springer: Berlin/Heidelberg, Germany, 2014; ISBN 978-1-4939-0761-8. [Google Scholar]
- Grillet, A.M.; Wyatt, N.B.; Gloe, L.M. Polymer Gel Rheology and Adhesion. Rheology 2012, 3, 59–80. [Google Scholar]
- Mezger, T.G. The Rheology Handbook: For Users of Rotational and Oscillatory Rheometers; Vincentz Network GmbH & Co KG: Hannover, Germany, 2006; ISBN 978-3-87870-174-3. [Google Scholar]
- Borzacchiello, A.; Ambrosio, L. Structure-Property Relationships in Hydrogels. In Hydrogels: Biological Properties and Applications; Barbucci, R., Ed.; Springer: Milan, Italy, 2009; pp. 9–20. ISBN 978-88-470-1104-5. [Google Scholar]
- Staicu, T.; Iliş, M.; Cîrcu, V.; Micutz, M. Influence of Hydrocarbon Moieties of Partially Fluorinated N-Benzoyl Thiourea Compounds on Their Gelation Properties. A Detailed Rheological Study of Complex Viscoelastic Behavior of Decanol/N-Benzoyl Thiourea Mixtures. J. Mol. Liq. 2018, 255, 297–312. [Google Scholar] [CrossRef]
- Galanakis, C.M. Nutraceutical and Functional Food Components: Effects of Innovative Processing Techniques; Academic Press: London, UK, 2017; ISBN 978-0-12-809650-5. [Google Scholar]
- Tort, S.; Demiröz, F.T.; Coşkun Cevher, Ş.; Sarıbaş, S.; Özoğul, C.; Acartürk, F. The Effect of a New Wound Dressing on Wound Healing: Biochemical and Histopathological Evaluation. Burns 2020, 46, 143–155. [Google Scholar] [CrossRef] [PubMed]
- Kharat, S.N.; Mendhulkar, V.D. Synthesis, Characterization and Studies on Antioxidant Activity of Silver Nanoparticles Using Elephantopus Scaber Leaf Extract. Mater. Sci. Eng. C Mater. Biol. Appl. 2016, 62, 719–724. [Google Scholar] [CrossRef] [PubMed]
- Priya, R.S.; Geetha, D.; Ramesh, P.S. Antioxidant Activity of Chemically Synthesized AgNPs and Biosynthesized Pongamia Pinnata Leaf Extract Mediated AgNPs—A Comparative Study. Ecotoxicol. Environ. Saf. 2016, 134, 308–318. [Google Scholar] [CrossRef] [PubMed]
- Patra, J.K.; Baek, K.-H. Biosynthesis of Silver Nanoparticles Using Aqueous Extract of Silky Hairs of Corn and Investigation of Its Antibacterial and Anticandidal Synergistic Activity and Antioxidant Potential. IET Nanobiotechnol 2016, 10, 326–333. [Google Scholar] [CrossRef] [PubMed]
- Mohanta, Y.K.; Panda, S.K.; Jayabalan, R.; Sharma, N.; Bastia, A.K.; Mohanta, T.K. Antimicrobial, Antioxidant and Cytotoxic Activity of Silver Nanoparticles Synthesized by Leaf Extract of Erythrina suberosa (Roxb.). Front. Mol. Biosci. 2017, 4, 14. [Google Scholar] [CrossRef]
- Caló, E.; Khutoryanskiy, V.V. Biomedical Applications of Hydrogels: A Review of Patents and Commercial Products. Eur. Polym. J. 2015, 65, 252–267. [Google Scholar] [CrossRef]
- Bhasarkar, J.; Bal, D. Kinetic Investigation of a Controlled Drug Delivery System Based on Alginate Scaffold with Embedded Voids. J. Appl. Biomater. Funct. Mater. 2019, 17, 2280800018817462. [Google Scholar] [CrossRef]
- Peppas, N.; Korsmeyer, R. Dynamically Swelling Hydrogel in Controlled Release Application. Hydrogels Med. Pharm. 1986, 3, 109–136. [Google Scholar]
- Khampieng, T.; Wnek, G.; Supaphol, P. Electrospun DOXY-h Loaded-Poly(Acrylic Acid) Nanofiber Mats: In Vitro Drug Release and Antibacterial Properties Investigation. J. Biomater. Sci. Polym. Ed. 2014, 25, 1–14. [Google Scholar] [CrossRef]
- Khampieng, T.; Wongkittithavorn, S.; Chaiarwut, S.; Ekabutr, P.; Pavasant, P.; Supaphol, P. Silver Nanoparticles-Based Hydrogel: Characterization of Material Parameters for Pressure Ulcer Dressing Applications. J. Drug Deliv. Sci. Technol. 2018, 44, 91–100. [Google Scholar] [CrossRef]
- Nguyen, T.D.; Nguyen, T.T.; Ly, K.L.; Tran, A.H.; Nguyen, T.T.N.; Vo, M.T.; Ho, H.M.; Dang, N.T.N.; Vo, V.T.; Nguyen, D.H.; et al. In Vivo Study of the Antibacterial Chitosan/Polyvinyl Alcohol Loaded with Silver Nanoparticle Hydrogel for Wound Healing Applications. Int. J. Polym. Sci. 2019, 2019, e7382717. [Google Scholar] [CrossRef]
- Archana, D.; Singh, B.K.; Dutta, J.; Dutta, P.K. Chitosan-PVP-Nano Silver Oxide Wound Dressing: In Vitro and in Vivo Evaluation. Int. J. Biol. Macromol. 2015, 73, 49–57. [Google Scholar] [CrossRef] [PubMed]
- Sondi, I.; Salopek-Sondi, B. Silver Nanoparticles as Antimicrobial Agent: A Case Study on E. Coli as a Model for Gram-Negative Bacteria. J. Colloid. Interface Sci. 2004, 275, 177–182. [Google Scholar] [CrossRef] [PubMed]
- Wang, T.; Zhang, F.; Zhao, R.; Wang, C.; Hu, K.; Sun, Y.; Politis, C.; Shavandi, A.; Nie, L. Polyvinyl Alcohol/Sodium Alginate Hydrogels Incorporated with Silver Nanoclusters via Green Tea Extract for Antibacterial Applications. Des. Monomers Polym. 2020, 23, 118–133. [Google Scholar] [CrossRef]
- Ahmed, E.M. Hydrogel: Preparation, Characterization, and Applications: A Review. J. Adv. Res. 2015, 6, 105–121. [Google Scholar] [CrossRef]
- Zakia, M.; Koo, J.M.; Kim, D.; Ji, K.; Huh, P.; Yoon, J.; Yoo, S.I. Development of Silver Nanoparticle-Based Hydrogel Composites for Antimicrobial Activity. Green. Chem. Lett. Rev. 2020, 13, 34–40. [Google Scholar] [CrossRef]
- Eghbalifam, N.; Frounchi, M.; Dadbin, S. Antibacterial Silver Nanoparticles in Polyvinyl Alcohol/Sodium Alginate Blend Produced by Gamma Irradiation. Int. J. Biol. Macromol. 2015, 80, 170–176. [Google Scholar] [CrossRef]
- Adhirajan, N.; Shanmugasundaram, N.; Shanmuganathan, S.; Babu, M. Functionally Modified Gelatin Microspheres Impregnated Collagen Scaffold as Novel Wound Dressing to Attenuate the Proteases and Bacterial Growth. Eur. J. Pharm. Sci. 2009, 36, 235–245. [Google Scholar] [CrossRef]
- Hafezi Moghaddam, R.; Dadfarnia, S.; Shabani, A.M.H.; Amraei, R.; Hafezi Moghaddam, Z. Doxycycline Drug Delivery Using Hydrogels of O-Carboxymethyl Chitosan Conjugated with Caffeic Acid and Its Composite with Polyacrylamide Synthesized by Electron Beam Irradiation. Int. J. Biol. Macromol. 2020, 154, 962–973. [Google Scholar] [CrossRef]
- Varshosaz, J.; Arabloo, K.; Sarrami, N.; Ghassami, E.; Yazdani Kachouei, E.; Kouhi, M.; Jahanian-Najafabadi, A. RGD Peptide Grafted Polybutylene Adipate-Co-Terephthalate/Gelatin Electrospun Nanofibers Loaded with a Matrix Metalloproteinase Inhibitor Drug for Alleviating of Wounds: An in Vitro/in Vivo Study. Drug Dev. Ind. Pharm. 2020, 46, 484–497. [Google Scholar] [CrossRef]
- Guo, S.; DiPietro, L.A. Factors Affecting Wound Healing. J. Dent. Res. 2010, 89, 219–229. [Google Scholar] [CrossRef]
- Basu, S.; Shukla, V. Complications of Wound Healing. In Measurements in Wound Healing: Science and Practice; Mani, R., Romanelli, M., Shukla, V., Eds.; Springer: London, UK, 2013; pp. 109–144. ISBN 978-1-4471-2987-5. [Google Scholar]
- Gushiken, L.F.S.; Beserra, F.P.; Bastos, J.K.; Jackson, C.J.; Pellizzon, C.H. Cutaneous Wound Healing: An Update from Physiopathology to Current Therapies. Life 2021, 11, 665. [Google Scholar] [CrossRef]
- Moore, A.L.; desJardins-Park, H.E.; Duoto, B.A.; Mascharak, S.; Murphy, M.P.; Irizarry, D.M.; Foster, D.S.; Jones, R.E.; Barnes, L.A.; Marshall, C.D.; et al. Doxycycline Reduces Scar Thickness and Improves Collagen Architecture. Ann. Surg. 2020, 272, 183–193. [Google Scholar] [CrossRef]
- Ghasemzadeh, H.; Ghanaat, F. Antimicrobial Alginate/PVA Silver Nanocomposite Hydrogel, Synthesis and Characterization. J. Polym. Res. 2014, 21, 355. [Google Scholar] [CrossRef]
- Rahmati, M.; Mozafari, M. Protein Adsorption on Polymers. Mater. Today Commun. 2018, 17, 527–540. [Google Scholar] [CrossRef]
- Yoon, J.-Y.; Kim, J.-H.; Kim, W.-S. The Relationship of Interaction Forces in the Protein Adsorption onto Polymeric microspheres1This Paper Was Presented in the 7th Iketani Conference—International Symposium on Advanced Technology of Fine Particles, October 1997, Yokohama Symposia, Japan.1. Colloids Surf. A Physicochem. Eng. Asp. 1999, 153, 413–419. [Google Scholar] [CrossRef]
- O’Brien, J.; Shea, K.J. Tuning the Protein Corona of Hydrogel Nanoparticles: The Synthesis of Abiotic Protein and Peptide Affinity Reagents. Acc. Chem. Res. 2016, 49, 1200–1210. [Google Scholar] [CrossRef]
- Catanzano, O.; Docking, R.; Schofield, P.; Boateng, J. Advanced Multi-Targeted Composite Biomaterial Dressing for Pain and Infection Control in Chronic Leg Ulcers. Carbohydr. Polym. 2017, 172, 40–48. [Google Scholar] [CrossRef]
- Avalos, A.; Haza, A.I.; Mateo, D.; Morales, P. Interactions of Manufactured Silver Nanoparticles of Different Sizes with Normal Human Dermal Fibroblasts. Int. Wound J. 2014, 13, 101–109. [Google Scholar] [CrossRef]
- Löfdahl, A.; Jern, A.; Flyman, S.; Kåredal, M.; Karlsson, H.L.; Larsson-Callerfelt, A.-K. Silver Nanoparticles Alter Cell Viability Ex Vivo and in Vitro and Induce Proinflammatory Effects in Human Lung Fibroblasts. Nanomaterials 2020, 10, 1868. [Google Scholar] [CrossRef]
- Gliga, A.R.; Skoglund, S.; Odnevall Wallinder, I.; Fadeel, B.; Karlsson, H.L. Size-Dependent Cytotoxicity of Silver Nanoparticles in Human Lung Cells: The Role of Cellular Uptake, Agglomeration and Ag Release. Part. Fibre Toxicol. 2014, 11, 11. [Google Scholar] [CrossRef]
- Akter, M.; Sikder, M.T.; Rahman, M.M.; Ullah, A.K.M.A.; Hossain, K.F.B.; Banik, S.; Hosokawa, T.; Saito, T.; Kurasaki, M. A Systematic Review on Silver Nanoparticles-Induced Cytotoxicity: Physicochemical Properties and Perspectives. J. Adv. Res. 2018, 9, 1–16. [Google Scholar] [CrossRef] [PubMed]
- Zhang, T.; Wang, L.; Chen, Q.; Chen, C. Cytotoxic Potential of Silver Nanoparticles. Yonsei Med. J. 2014, 55, 283. [Google Scholar] [CrossRef] [PubMed]
- Cui, S.; Sun, X.; Li, K.; Gou, D.; Zhou, Y.; Hu, J.; Liu, Y. Polylactide Nanofibers Delivering Doxycycline for Chronic Wound Treatment. Mater. Sci. Eng. C Mater. Biol. Appl. 2019, 104, 109745. [Google Scholar] [CrossRef]
- de A Vieira, L.F.; Lins, M.P.; Viana, I.M.M.N.; dos Santos, J.E.; Smaniotto, S.; Reis, M.D. dos S. Metallic Nanoparticles Reduce the Migration of Human Fibroblasts in Vitro. Nanoscale Res. Lett. 2017, 12, 200. [Google Scholar] [CrossRef] [PubMed]
- Chang, W.Y.C.; Clements, D.; Johnson, S.R. Effect of Doxycycline on Proliferation, MMP Production, and Adhesion in LAM-Related Cells. Am. J. Physiol. Lung Cell. Mol. Physiol. 2010, 299, L393–L400. [Google Scholar] [CrossRef] [PubMed]
- Shin, J.-M.; Kang, J.-H.; Lee, S.-A.; Park, I.-H.; Lee, H.-M. Effect of Doxycycline on Epithelial-Mesenchymal Transition via the P38/Smad Pathway in Respiratory Epithelial Cells. Am. J. Rhinol. Allergy 2017, 31, 71–77. [Google Scholar] [CrossRef] [PubMed]
- Chang, H.-F.; Cheng, H.-T.; Chen, H.-Y.; Yeung, W.K.; Cheng, J.-Y. Doxycycline Inhibits Electric Field-Induced Migration of Non-Small Cell Lung Cancer (NSCLC) Cells. Sci. Rep. 2019, 9, 8094. [Google Scholar] [CrossRef] [PubMed]
- Masood, N.; Ahmed, R.; Tariq, M.; Ahmed, Z.; Masoud, M.S.; Ali, I.; Asghar, R.; Andleeb, A.; Hasan, A. Silver Nanoparticle Impregnated Chitosan-PEG Hydrogel Enhances Wound Healing in Diabetes Induced Rabbits. Int. J. Pharm. 2019, 559, 23–36. [Google Scholar] [CrossRef]
- Chandrasekharan, S.; Chinnasamy, G.; Bhatnagar, S. Sustainable Phyto-Fabrication of Silver Nanoparticles Using Gmelina Arborea Exhibit Antimicrobial and Biofilm Inhibition Activity. Sci. Rep. 2022, 12, 156. [Google Scholar] [CrossRef] [PubMed]
- Xing, W.; Tang, Y. On Mechanical Properties of Nanocomposite Hydrogels: Searching for Superior Properties. Nano Mater. Sci. 2022, 4, 83–96. [Google Scholar] [CrossRef]
- Xu, D.; Gersappe, D. Structure Formation in Nanocomposite Hydrogels. Soft Matter 2017, 13, 1853–1861. [Google Scholar] [CrossRef] [PubMed]

| Sample | HM20-Ag | HM100-Ag | HM0.3-Dox | HM5-Dox | HM-C | HM-Cp |
|---|---|---|---|---|---|---|
| PVA | 2.3% (m/v) | 2.3% (m/v) | 2.3% (m/v) | 2.3% (m/v) | 2.3% (m/v) | 2.3% (m/v) |
| Alginate | 0.6% (m/v) | 0.6% (m/v) | 0.6% (m/v) | 0.6% (m/v) | 0.6% (m/v) | 0.6% (m/v) |
| Glycerol | 8.57% (v/v) | 8,57% (v/v) | 8.57% (v/v) | 8.57% (v/v) | 8.57% (v/v) | 8.57% (v/v) |
| CaCl2 | 0.075% (m/v) | 0.075% (m/v) | 0.075% (m/v) | 0.075% (m/v) | 0.075% (m/v) | 0.075% (m/v) |
| Hyaluronic Acid | 2 µg/mL | 2 µg/mL | 2 µg/mL | 2 µg/mL | 2 µg/mL | - |
| Collagen | 35 µg/mL | 35 µg/mL | 35 µg/mL | 35 µg/mL | 35 µg/mL | - |
| npAg 20 nm | 10 µg/mL | - | - | - | - | - |
| npAg 100 nm | - | 10 µg/mL | - | - | - | - |
| Doxycycline | - | - | 0.3 mg/mL | 5 mg/mL | - | - |
| Sample | Radius (mm) | Gap (Sample Thickness) (µm) | Amplitude of the Vertical Displacement (µm) |
|---|---|---|---|
| HM-C | 9.1 | 730 | 0.04 |
| HM20-Ag | 9.8 | 700 | 0.04 |
| HM100-Ag | 9.5 | 720 | 0.04 |
| HM0.3-Dox | 9.1 | 780 | 0.04 |
| HM5-Dox | 9.1 | 770 | 0.04 |
| Sample | Weight (g) | Thickness (mm) | pH |
|---|---|---|---|
| HM20-Ag | 4.98 ± 0.19 | 4.5 ± 0.32 | 7.3 ± 0.02 |
| HM100-Ag | 4.92 ± 0.32 | 4.45 ± 0.47 | 7.29 ± 0.01 |
| HM0.3-Dox | 5.41 ± 0.13 | 4.78 ± 0.26 | 7.14 ± 0.02 |
| HM5-Dox | 5.47 ± 0.17 | 4.8 ± 0.18 | 4.62 ± 0.03 |
| HM-C | 4.80 ± 0.15 | 4.35 ± 0.38 | 7.34 ± 0.05 |
| Sample | Zero-Order Kinetic | First-Order Kinetic | Higuchi Model | Kosmeyer Peppas Model | |||||
|---|---|---|---|---|---|---|---|---|---|
| K | R2 | K (h−1) | R2 | K (h−1/2) | R2 | K (h−n) | n | R2 | |
| HM0.3-Dox | 0.3426 | 0.3096 | −0.0016 | 0.3188 | 2.4706 | 0.5994 | 0.82783 | 0.165079 | 0.943085 |
| HM5-Dox | 0.416 | 0.1411 | −0.0019 | 0.1405 | 2.4406 | 0.3776 | 4.05068 | 0.051096 | 0.997314 |
| Bacterial Strain | Inhibition Zone in mm (Duplicate) | |||||||||||||
|---|---|---|---|---|---|---|---|---|---|---|---|---|---|---|
| HM20-Ag | HM100-Ag | HM0.3-Dox | HM5-Dox | HM-C | HM-Cp | DOXI Standard Disk | ||||||||
| S. epidermidis | 0 | 0 | 0 | 0 | 17 | 17 | 30 | 30 | 0 | 0 | 0 | 0 | 17 | 16 |
| S. aureus | 0 | 0 | 0 | 0 | 19 | 19 | 30 | 30 | 0 | 0 | 0 | 0 | 17 | 17 |
| E. faecalis | 0 | 0 | 0 | 0 | 25 | 25 | 31 | 30 | 0 | 0 | 0 | 0 | 25 | 25 |
| S. pyogenes | 0 | 0 | 0 | 0 | 25 | 24 | 38 | 35 | 0 | 0 | 0 | 0 | 25 | 25 |
| P. aeruginosa | 0 | 0 | 0 | 0 | 18 | 15 | 28 | 26 | 0 | 0 | 0 | 0 | 17 | 18 |
| A. baumannii | 0 | 0 | 0 | 0 | 28 | 30 | 35 | 35 | 0 | 0 | 0 | 0 | 26 | 28 |
| K. pneumoniae | 0 | 0 | 0 | 0 | 17 | 15 | 25 | 25 | 0 | 0 | 0 | 0 | 16 | 15 |
Disclaimer/Publisher’s Note: The statements, opinions and data contained in all publications are solely those of the individual author(s) and contributor(s) and not of MDPI and/or the editor(s). MDPI and/or the editor(s) disclaim responsibility for any injury to people or property resulting from any ideas, methods, instructions or products referred to in the content. |
© 2023 by the authors. Licensee MDPI, Basel, Switzerland. This article is an open access article distributed under the terms and conditions of the Creative Commons Attribution (CC BY) license (https://creativecommons.org/licenses/by/4.0/).
Share and Cite
Stan, D.; Ruta, L.L.; Bocancia-Mateescu, L.-A.; Mirica, A.-C.; Stan, D.; Micutz, M.; Brincoveanu, O.; Enciu, A.-M.; Codrici, E.; Popescu, I.D.; et al. Formulation and Comprehensive Evaluation of Biohybrid Hydrogel Membranes Containing Doxycycline or Silver Nanoparticles. Pharmaceutics 2023, 15, 2696. https://doi.org/10.3390/pharmaceutics15122696
Stan D, Ruta LL, Bocancia-Mateescu L-A, Mirica A-C, Stan D, Micutz M, Brincoveanu O, Enciu A-M, Codrici E, Popescu ID, et al. Formulation and Comprehensive Evaluation of Biohybrid Hydrogel Membranes Containing Doxycycline or Silver Nanoparticles. Pharmaceutics. 2023; 15(12):2696. https://doi.org/10.3390/pharmaceutics15122696
Chicago/Turabian StyleStan, Diana, Lavinia Liliana Ruta, Lorena-Andreea Bocancia-Mateescu, Andreea-Cristina Mirica, Dana Stan, Marin Micutz, Oana Brincoveanu, Ana-Maria Enciu, Elena Codrici, Ionela Daniela Popescu, and et al. 2023. "Formulation and Comprehensive Evaluation of Biohybrid Hydrogel Membranes Containing Doxycycline or Silver Nanoparticles" Pharmaceutics 15, no. 12: 2696. https://doi.org/10.3390/pharmaceutics15122696
APA StyleStan, D., Ruta, L. L., Bocancia-Mateescu, L.-A., Mirica, A.-C., Stan, D., Micutz, M., Brincoveanu, O., Enciu, A.-M., Codrici, E., Popescu, I. D., Popa, M. L., Rotaru, F., & Tanase, C. (2023). Formulation and Comprehensive Evaluation of Biohybrid Hydrogel Membranes Containing Doxycycline or Silver Nanoparticles. Pharmaceutics, 15(12), 2696. https://doi.org/10.3390/pharmaceutics15122696

